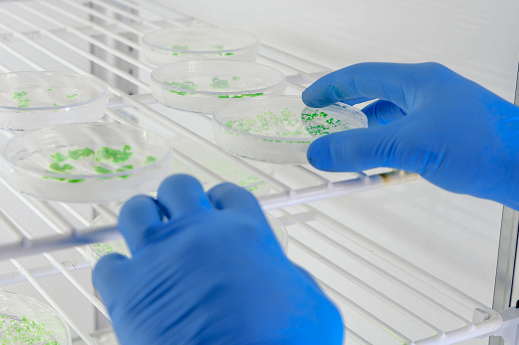
Imagem: foto de duas mãos com luvas azuis pegando um material redondo de vidro com substâncias verdes dentro de um refrigerador

Medicina Tropical: Abertas inscrições para encontros internacionais organizados pelo Núcleo de Biomedicina da UFC
- Sexta, 08 Abril 2022 15:16
Estão abertas as inscrições para o XXIV Tropical Medicine Research Center & Pharmacology e III International Symposium on Neurogastroenterology and Motility. Os encontros integram um único evento, organizado pelo Núcleo de Biomedicina (NUBIMED) da Faculdade de Medicina da 55BET Zone Brasil – Apostas Esportivas e Futebol Online Federal do Ceará, sendo gratuito e aberto ao público.
O evento tem o objetivo de contribuir para o desenvolvimento de pesquisas relacionadas a medicina tropical e higiene e farmacologia, sendo um espaço para reunir pesquisas sobre saúde pública, principalmente as relacionadas a questões envolvendo a região semiárida brasileira.
Neste ano, as atividades serão virtuais e ocorrerão nos dias 5 e 6 maio. Dividido em quatro sessões, o evento contará com palestras de acadêmicos e apresentações orais de estudantes de pós-graduação sobre os principais problemas de saúde pública, abordando temas como desnutrição, doenças diarreicas e leishmaniose. Destaque para a manhã do dia 6 de maio, que terá uma sessão dedicada à influenza e ao vírus SARS-CoV-2.
Além de pesquisadores nacionais, o encontro contará com a participação dos professores Daniel Sifrim, que atua na Queen Mary University of London, e David Criddle, docente da University of Liverpool. A programação completa está disponível no site do evento.
HISTÓRICO – O encontro do Tropical Medicine Research Center surgiu em 1996 ao reunir professores, pesquisadores e estudantes interessados no desenvolvimento científico e tecnológico de pesquisas sobre doenças tropicais que afligem populações do semiárido brasileiro, como leishmaniose, leptospirose, doenças diarreicas, enteropatia tropical, desnutrição, vírus linfotrópico T humano (HTLV), hanseníase, tuberculose, entre outras.
Ao longo do tempo, o evento foi ampliado para o setor de farmacologia, passando a contar também com a participação de institutos nacionais de ciência e tecnologia, como o de Biomedicina no Semiárido Brasileiro, e, mais recentemente, expandiu as discussões para as áreas de neurogastroenterologia e motilidade.
Fonte: Prof. Armênio Aguiar dos Santos, do Departamento de Fisiologia e Farmacologia da UFC e integrante da comissão científica do evento – e-mail: Este endereço de email está sendo protegido de spambots. Você precisa do JavaScript ativado para vê-lo.







